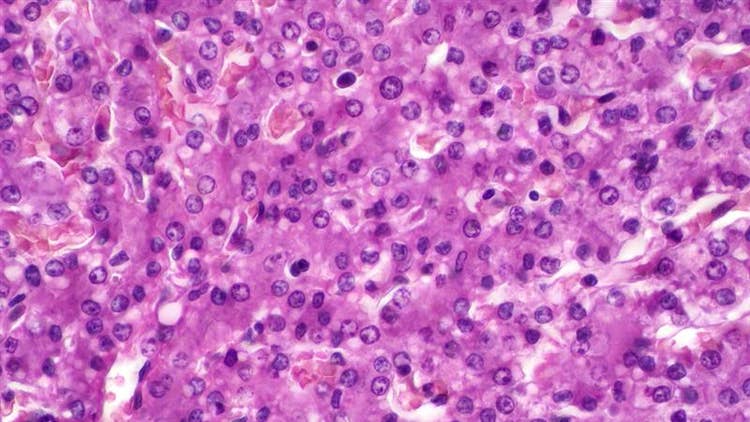

How AI and 3D Liver Models Are Changing Drug Safety Testing
Why This Matters
Drug-induced liver injury (DILI) is a leading contributor to drug recalls and late-stage failures in clinical trials. Traditional 2D cell cultures and animal models often fail to accurately predict human-specific toxicity, underscoring the urgent need for more physiologically relevant systems. Human 3D liver microtissues offer a promising solution, providing a closer approximation of in vivo liver structure and function. When combined with artificial intelligence (AI) and machine learning (ML), these models enable high-throughput, automated toxicity screening with improved accuracy and efficiency.
How can we predict liver toxicity earlier and more accurately?
In an AI-assisted screening study, researchers used 3D liver microtissues (3D Insight™ Liver Model) to develop an imaging-based in vitro assay for toxicity evaluation. Using a cell painting assay, a multiplexed fluorescent imaging technique was applied to capture key phenotypic changes. ImageXpress HCS.ai High-Content Screening System from Molecular Devices generated thousands of images per compound treatment, which were analyzed using machine learning by IN Carta software to identify early compound effects.

What They Found
The AI-assisted workflow classified liver microtissues into “intact” or “damaged” phenotypes based on extracted morphological features. Key findings include:
- Compound-specific toxicity signatures for high classification accuracy
- Early detection of toxicity using ML models to identify patterns across multiple cellular compartments
- AI-driven predictions align closely with traditional biochemical assays, validating the approach

Benefits for Drug Development
AI-powered analysis of human 3D liver microtissues represents a transformative approach to toxicity screening. This integrated platform offers several advantages:
- Scalability for high-throughput screening
- Sensitivity to detect early phenotypic changes before cell death
- Human relevance for better prediction of real-world toxicity
Learn how Molecular Devices, a life sciences company of Danaher, can help you leverage 3D liver models, advanced imaging and AI to accelerate drug safety assessments and minimize late-stage failures.
Contact an expert to discover how to pave the way for safer and more efficient drug development.